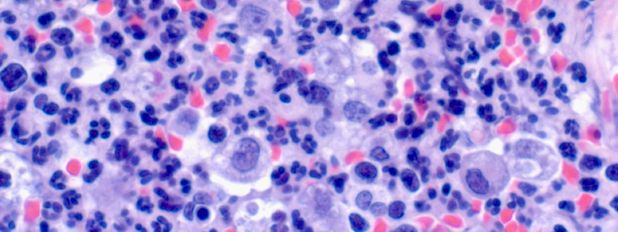
������� 3 � ������������� ���� ������ ��� ������� �����������

Изучение форменных элементов крови
Изучение форменных элементов крови
|
|
Пособие составлено с учётом особенностей преподавания гистологии для студентов, обучающихся по очной и заочной формам обучения. В нем отражены вопросы, наиболее часто задаваемые студентами и вызывающие наибольшие затруднения.
К данным особенностям можно отнести следующее.
1. Изучение мазков крови человека, а не сельскохозяйственных животных. Это связано с наличием учебных препаратов «Мазок крови человека», которыми централизованно снабжались высшие учебные заведения. Кроме того, строение форменных элементов крови большинства видов сельскохозяйственных животных и человека имеет значительное сходство. Поэтому, в случае освоения навыков работы с препаратами крови человека, дальнейшая работа с мазками крови животных не вызовет затруднений.
2. Работа с препаратами, окрашенными гематоксилином и эозином. Данная особенность также связана с наличием учебных препаратов, окрашенных гематоксилином и эозином, а не по методу Романовского-Гимзы, по которому принято окрашивать мазки крови в диагностических лабораториях.
Препараты крови, окрашенные по методу Романовского-Гимзы, имеют некоторые отличия от препаратов, окрашенных гематоксилином и эозином. Общим для двух методов является окрашивание эритроцитов в розовый цвет, ядер лейкоцитов – в синий. Отличия касаются окраски цитоплазмы лейкоцитов: в первом случае она серо-голубая (чем больше РНК содержится в цитоплазме, тем больше преобладает синий цвет), во втором – розовая. Преимуществом окраски по методу Романовского-Гимзы является лучшее выявление зернистости в цитоплазме гранулоцитов. Однако навыки идентификации лейкоцитов, окрашенных гематоксилином и эозином, также необходимы морфологу, поскольку в большинстве гистологических исследований препараты окрашивают гематоксилином и эозином. Определение вида лейкоцитов в тканях в ходе гистологического исследования часто имеет диагностическое значение.
Помимо особенностей окраски, в гистологических препаратах форменные элементы крови имеют иную форму, поскольку они не распластаны на стекле, а находятся свободно либо бывают сдавлены окружающими структурами. На рис. 1-3 представлены ситуации, когда от выявления лейкоцитов определённого вида в исследуемых тканях зависит постановка диагноза.
Представленные в пособии фотографии выполнены с препаратов, окрашенных гематоксилином и эозином (за исключением рис. 21 и 40).
|
|
Рисунок 3 – Лимфатический узел собаки при гнойном лимфадените. Препарат содержит множество сегментоядерных нейтрофильных гранулоцитов |
3. Работа без иммерсии. Изучение морфологии форменных элементов крови рекомендуют проводить при 900-1500-кратном увеличении. Данное увеличение получают при помощи иммерсионных объективов. В диагностических лабораториях подсчёт лейкоцитарной формулы также выполняют с использованием иммерсионных объективов. На практических занятиях по гистологии микроскопированием с иммерсией пользуются редко, поскольку неполное удаление иммерсионного масла ведёт к порче объектива. Обычно на практических занятиях препараты рассматривают при помощи неиммерсионных объективов при 400-600-кратном увеличении. Данного увеличения вполне достаточно для уверенной идентификации клеток (в случае знания их морфологии). Кроме того, гистологические исследования, в ходе которых определяют виды лейкоцитов в тканях, также проводят без использования иммерсии.
Для увеличения сходства фотографий, представленных в пособии, с картиной, наблюдаемой в микроскоп на практическом занятии, все фотографии выполнены без иммерсии. Площадь препарата, представленная на фотографиях, примерно соответствует полю зрения учебного микроскопа. С этой же целью поля зрения выбраны случайным образом, кадрирования и улучшения качества изображений не проводилось, фотографии содержат изображения артефактов, имеющихся в учебных препаратах.

|

|
|
|
© ФГБОУ ВО Новосибирский ГАУ |
||